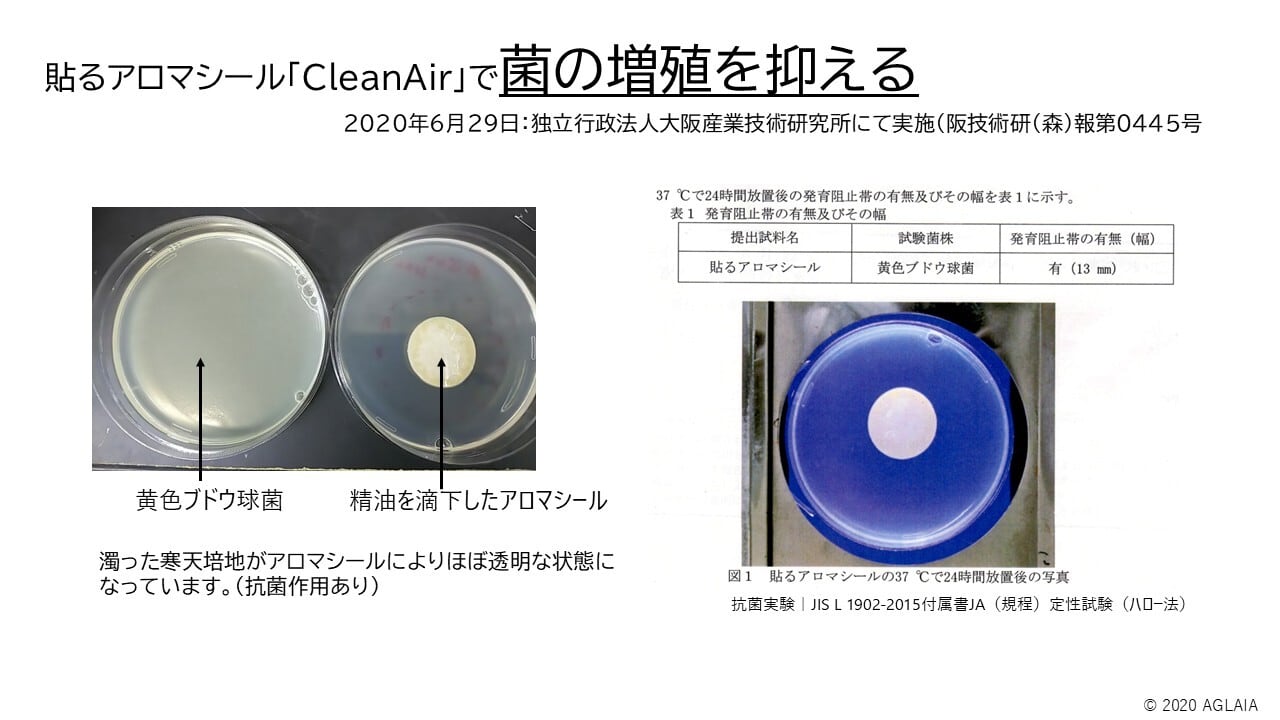

1/8
【特別価格・特許取得済】業務用ピタッとアロマクリア20φサイズ(1シート12つき)100シート入
¥11,000
International shipping available
衣服やマスク、下着など好きな場所にはることができます。1シート12pつきが100シート入っています。
2025年の夏、再び新型コロナウイルスが流行しています。感染すると、特に喉の強い痛みが報告されているようです。
そんな時期のマスク生活を少しでも快適にするために、**ハッカ油・レモン・ペパーミントなどの清涼感ある精油を使った「アロマシール」**がおすすめです。
マスクにアロマシールを貼ることで、以下のような効果が期待できます(マスクに貼るぴったりサイズ)
• 抗菌作用:精油の成分には抗菌性があり、マスク内の衛生環境をサポートします(※データあり)。
• 消臭効果:香りで不快なニオイをごまかすのではなく、根本から消臭。
• 清涼感アップ:爽やかな香りが、暑さや息苦しさを和らげてくれます。
香りの力で、心も身体も少し軽くなるようなマスク習慣を取り入れてみませんか?
医療現場から生まれた精油・香料滴下専用シール
臨床アロマを実施している弊社ならではの香りの拡散方法。パーソナルスペースのみ(約50㎝)香りを感じ、ご本人だけ香りを感じることができます。使い捨てのため衛生的。
貼るアロマシールは、香りに対して様々な感情をお持ちの患者様がおられる院内等でも多数活用され香りを使った様々な疾患への臨床研究にも利用されています。
そのため、素材を厳選し、香りが生きるようすべて国内生産・安心素材製造です。
最近チェックした商品
同じカテゴリの商品
その他の商品
CATEGORY